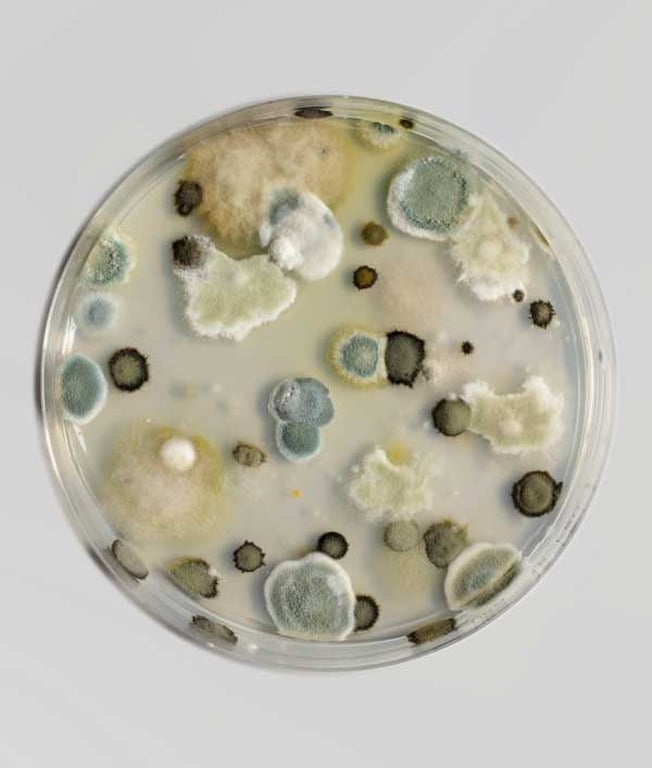
Εικόνα επιλογής

Παρουσίαση/Προβολή
ΕΙΔΙΚΗ ΦΥΤΟΠΑΘΟΛΟΓΙΑ - ΕΡΓΑΣΤΗΡΙΟ
(3226) - ΑΝΝΑ ΚΟΣΤΡΙΒΑ - ΒΑΣΙΛΗΣ ΔΗΜΟΠΟΥΛΟΣ
Περιγραφή Μαθήματος
ΠΕΡΙΕΧΟΜΕΝΟ ΜΑΘΗΜΑΤΟΣ
Το μάθημα αποσκοπεί στην παροχή προς τους φοιτητές/τριες των αναγκαίων γνώσεων για την αναγνώριση και αντιμετώπιση των παρασιτικών και μη παρασιτικών ασθενειών στις των σημαντικότερων καλλιεργειών στον Ελλαδικό χώρο.
Με την επιτυχή ολοκλήρωση του μαθήματος, οι φοιτητές/τριες θα είναι ικανοί/ες να:
- αναγνωρίζουν τα συμπτώματα και τα σημεία των κυριότερων ασθενειών που οφείλονται σε μικροοργανισμούς (μύκητες, βακτήρια, ιούς) αλλά και ελλείψεις θρεπτικών στοιχείων (τροφοπενίες) στις σημαντικότερες καλλιέργειες (δενδρώδεις, κηπευτικά, ανθοκομικά, φυτά μεγάλης καλλιέργειας)
- εκτιμούν τις αναμενόμενες επιπτώσεις επί των ποσοτικών και ποιοτικών χαρακτηριστικών της παραγωγής
- καταρτίζουν και εφαρμόζουν προγράμματα ολοκληρωμένης φυτοπροστασίας με γνώμονα την ασφάλεια των παραγωγών των καταναλωτών και την προστασία του περιβάλλοντος
Εργαστήριο (2 ώρες / εβδομάδα)
- Αναγνώριση των κυριότερων φυτοπαθογόνων μυκήτων βάσει των μορφολογικών χαρακτηριστικών τους
- Απομόνωση και ταυτοποίηση φυτοπαθογόνων μυκήτων από φυτικούς ιστούς
- Αναγνώριση των συμπτωμάτων και των σημείων των σημαντικότερων παρασιτικών και μη παρασιτικών ασθενειών όπως αυτά εκφράζονται στις κύριες καλλιέργειες δενδρωδών, κηπευτικών ανθοκομικών και φυτών μεγάλης καλλιέργειας
ΤΡΟΠΟΣ ΠΑΡΑΔΟΣΗΣ
Εργαστήριο: ασκήσεις σε ομάδες των 20 φοιτητών /τριών, χρήση εργαστηριακού εξοπλισμού και ηλεκτρονικών εποπτικών μέσων
ΑΞΙΟΛΟΓΗΣΗ
Εργαστήριο: γραπτή τελική εξέταση που περιλαμβάνει ερωτήσεις πολλαπλής επιλογής (50% της βαθμολογίας), τελική εξέταση επί των εργαστηριακών ασκήσεων (20% της βαθμολογίας), γραπτή εργασία (30% της βαθμολογίας).
ΑμΕΑ: προφορική εξέταση
ΒΙΒΛΙΟΓΡΑΦΙΑ
- Παναγόπουλος Χ., Ασθένειες Κηπευτικών Καλλιεργειών, Εκδόσεις Σταμούλης, 1995
- Παναγόπουλος Χ., Ασθένειες Καλλωπιστικών Φυτών, Εκδόσεις Σταμούλης, 2003
- Παναγόπουλος Χ., Ασθένειες Καρποφόρων Δένδρων και Αμπέλου, Εκδόσεις Σταμούλης, 2007
Ημερομηνία δημιουργίας
Τρίτη 28 Φεβρουαρίου 2023
-
Δεν υπάρχει περίγραμμα
